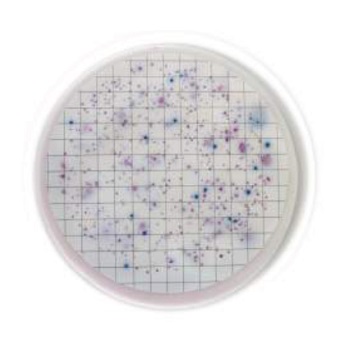

Cargando, por favor espere ...

Material para ensayos y análisis microbiológicos
| Código | Descripción | Disponibilidad | Precio 1x (€) |
Cantidad | Añadir | Precio 1x caja (€) |
Cantidad caja |
Añadir |
|---|---|---|---|---|---|---|---|---|
| 2135101011 | Easy Dry Chromatic Coliform ISO, 100 pads, Dry media in 60 mm petri dishes, packed in 10 piles of 10 pads, LIOFILCHEM® | 5/12 días | 229,43 | 1 | 167,12 | 5 | ||
| 2135101012 | Easy Dry Tryptic Soy, 100 pads, Dry media in 60 mm petri dishes, packed in 10 piles of 10 pads, LIOFILCHEM® | 5/12 días | 229,43 | 1 | 167,12 | 5 | ||
| 2135101013 | Easy Dry Yeast Extract, 100 pads, Dry media in 60 mm petri dishes, packed in 10 piles of 10 pads, LIOFILCHEM® | 5/12 días | 229,43 | 1 | 167,12 | 5 | ||
| 2135101014 | Easy Dry MacConkey, 100 pads, Dry media in 60 mm petri dishes, packed in 10 piles of 10 pads, LIOFILCHEM® | 5/12 días | 229,43 | 1 | 167,12 | 5 | ||
| 2135101015 | Easy Dry Chromatic Salmonella, 100 pads, Dry media in 60 mm petri dishes, packed in 10 piles of 10 pads, LIOFILCHEM® | 5/12 días | 229,43 | 1 | 167,12 | 5 | ||
| 2135101016 | Easy Dry C-EC MF, 100 pads, Dry media in 60 mm petri dishes, packed in 10 piles of 10 pads, LIOFILCHEM® | 5/12 días | 229,43 | 1 | 167,12 | 5 | ||
| 2135101017 | Easy Dry Tergitol, 100 pads, Dry media in 60 mm petri dishes, packed in 10 piles of 10 pads, LIOFILCHEM® | 5/12 días | 229,43 | 1 | 167,12 | 5 | ||
| 2135101018 | Easy Dry Tergitol + TTC, 100 pads, Dry media in 60 mm petri dishes, packed in 10 piles of 10 pads, LIOFILCHEM® | 5/12 días | 229,43 | 1 | 167,12 | 5 | ||
| 2135101019 | Easy Dry Chromatic Coli Coliform, 100 pads, Dry media in 60 mm petri dishes, packed in 10 piles of 10 pads, LIOFILCHEM® | 5/12 días | 229,43 | 1 | 167,12 | 5 | ||
| 2135101020 | Easy Dry M-Green Yeast & Mould, 100 pads, Dry media in 60 mm petri dishes, packed in 10 piles of 10 pads, LIOFILCHEM® | 5/12 días | 229,43 | 1 | 167,12 | 5 | ||
| 2135101021 | Easy Dry Sabouraud Dextrose, 100 pads, Dry media in 60 mm petri dishes, packed in 10 piles of 10 pads, LIOFILCHEM® | 5/12 días | 229,43 | 1 | 167,12 | 5 | ||
| 2135101022 | Easy Dry Streptococcal KF + TTC, 100 pads, Dry media in 60 mm petri dishes, packed in 10 piles of 10 pads, LIOFILCHEM® | 5/12 días | 229,43 | 1 | 167,12 | 5 | ||
| 2135101023 | Easy Dry Plate Count + TTC, 100 pads, Dry media in 60 mm petri dishes, packed in 10 piles of 10 pads, LIOFILCHEM® | 5/12 días | 229,43 | 1 | 167,12 | 5 | ||
| 2135101024 | Easy Dry Violet Red Bile Glucose, 100 pads, Dry media in 60 mm petri dishes, packed in 10 piles of 10 pads, LIOFILCHEM® | 5/12 días | 229,43 | 1 | 167,12 | 5 | ||
| 2135101025 | Easy Dry TBX, 100 pads, Dry media in 60 mm petri dishes, packed in 10 piles of 10 pads, LIOFILCHEM® | 5/12 días | 229,43 | 1 | 167,12 | 5 | ||
| 2135101026 | Easy Dry m-Endo LES, 100 pads, Dry media in 60 mm petri dishes, packed in 10 piles of 10 pads, LIOFILCHEM® | 5/12 días | 229,43 | 1 | 167,12 | 5 | ||
| 2135101027 | Easy Dry Pseudomonas CN, 100 pads, Dry media in 60 mm petri dishes, packed in 10 piles of 10 pads, LIOFILCHEM® | 5/12 días | 229,43 | 1 | 167,12 | 5 | ||
| 2135101028 | Easy Dry m-Faecal Coliform, 100 pads, Dry media in 60 mm petri dishes, packed in 10 piles of 10 pads, LIOFILCHEM® | 5/12 días | 229,43 | 1 | 167,12 | 5 | ||
| 2135101029 | Easy Dry Slanetz Bartley, 100 pads, Dry media in 60 mm petri dishes, packed in 10 piles of 10 pads, LIOFILCHEM® | 5/12 días | 229,43 | 1 | 167,12 | 5 | ||
| 2135101030 | Easy Dry Bile Aesculin Azide, 100 pads, Dry media in 60 mm petri dishes, packed in 10 piles of 10 pads, LIOFILCHEM® | 5/12 días | 229,43 | 1 | 167,12 | 5 | ||
| 2135101031 | Easy Dry Orange Serum, 100 pads, Dry media in 60 mm petri dishes, packed in 10 piles of 10 pads, LIOFILCHEM® | 5/12 días | 229,43 | 1 | 167,12 | 5 |